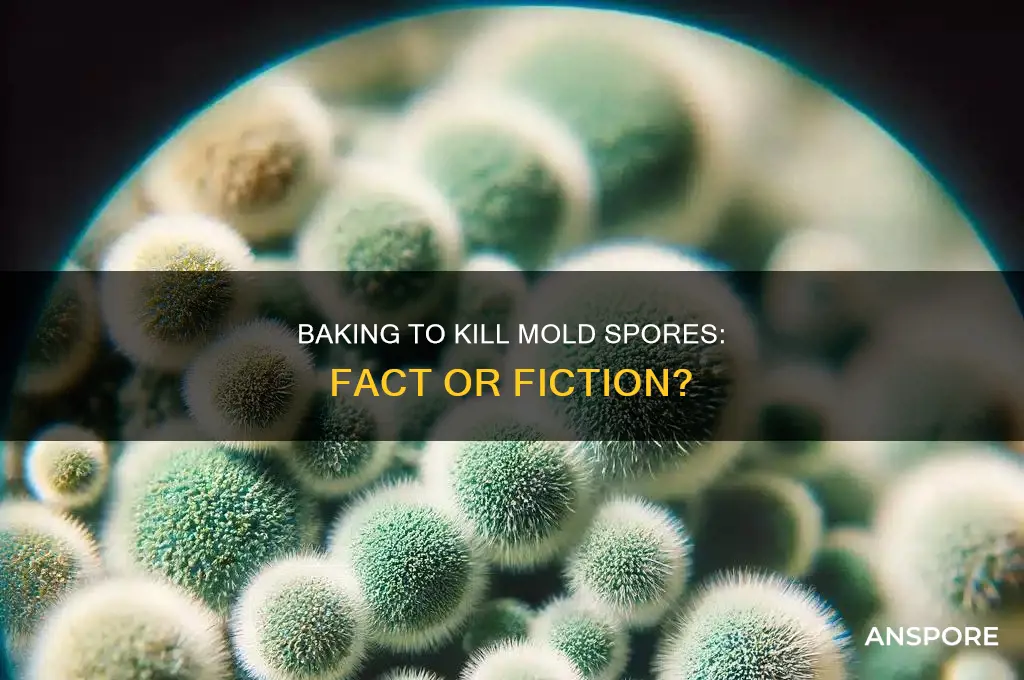
does baking kill mold spores

Baking is often considered a reliable method for killing bacteria and other pathogens in food, but when it comes to mold spores, the effectiveness is less straightforward. Mold spores are highly resilient and can survive extreme conditions, including high temperatures. While baking at typical temperatures (around 350°F or 175°C) may kill some surface mold, it is unlikely to eliminate deeply embedded spores, which can remain dormant and potentially regrow under favorable conditions. Therefore, it is generally recommended to discard moldy items rather than relying on baking as a solution, as consuming mold spores can pose health risks.
| Characteristics | Values |
|---|---|
| Effectiveness of Baking on Mold Spores | Baking at temperatures above 140°F (60°C) can kill most mold spores, but not all. Some spores are heat-resistant and may survive. |
| Temperature Requirement | Minimum 140°F (60°C) for effectiveness; higher temperatures (e.g., 300°F/150°C) are more reliable for killing spores. |
| Duration | Prolonged exposure (e.g., 30 minutes or more) at the required temperature increases effectiveness. |
| Type of Mold | Some mold species (e.g., Aspergillus, Penicillium) are more heat-resistant than others. |
| Material Impact | Baking may damage certain materials (e.g., plastics, delicate fabrics) if not suitable for high temperatures. |
| Surface vs. Porous Materials | Baking is more effective on non-porous surfaces; porous materials may retain spores even after baking. |
| Residual Toxins | Baking does not eliminate mycotoxins produced by mold, which can remain harmful even after spores are killed. |
| Alternative Methods | Steam cleaning, vinegar, or commercial mold killers may be more effective or safer for certain materials. |
| Safety Concerns | Inhaling mold spores during baking can be hazardous; proper ventilation and protective gear are essential. |
| Prevention | Baking is not a substitute for addressing moisture issues, which are the root cause of mold growth. |
Explore related products
What You'll Learn

Heat Threshold for Mold Spores
Mold spores are remarkably resilient, capable of surviving in environments that would destroy most other microorganisms. However, their survival is not infinite, especially when exposed to heat. The critical question is: at what temperature do mold spores meet their threshold for destruction? Research indicates that mold spores begin to die off when exposed to temperatures above 140°F (60°C). This temperature is not arbitrarily chosen but is based on the structural limits of the spore’s cell walls and internal components. For instance, *Aspergillus* and *Penicillium* spores, common culprits in food and household mold, are particularly resistant but still succumb when temperatures exceed this range for prolonged periods.
To effectively kill mold spores through heat, the duration of exposure is as crucial as the temperature itself. Baking at 300°F (150°C) for 30 minutes, for example, can significantly reduce spore viability, but this method is not foolproof for all materials. Porous items like bread or fabric may retain spores in crevices where heat penetration is uneven. Non-porous items, such as glass or metal, fare better under these conditions because heat distributes uniformly. A practical tip: use a food thermometer to ensure the internal temperature of the item reaches the desired threshold, especially when dealing with dense foods like casseroles or baked goods.
Comparatively, industrial methods often employ higher temperatures for guaranteed spore eradication. Autoclaves, for instance, use steam at 250°F (121°C) under pressure for 15–30 minutes, a standard in laboratory settings. This method is overkill for home use but illustrates the principle that higher temperatures and controlled environments are more effective. For home bakers, a conventional oven set to 350°F (175°C) for 45–60 minutes can be a reliable alternative, though it may alter the texture of certain foods. Always prioritize safety: avoid inhaling spores during preparation, and discard items if mold infestation is severe.
A cautionary note: not all materials can withstand high temperatures. Plastics, for example, may warp or release toxins when heated above their melting point. Similarly, certain foods lose nutritional value or become unsafe when overheated. For instance, oils can oxidize and become harmful when baked at temperatures exceeding 350°F (175°C). Always research the heat tolerance of the material or food in question before attempting to kill mold spores through baking. When in doubt, disposal is the safest option, particularly for items with high sentimental or monetary value that cannot be replaced.
In conclusion, understanding the heat threshold for mold spores empowers individuals to make informed decisions about salvaging contaminated items. While baking can be an effective method, it requires precision in temperature and duration. For porous materials or severe infestations, heat treatment may not suffice, and professional remediation or disposal is recommended. By combining scientific knowledge with practical application, one can navigate the challenge of mold spores with confidence and safety.
Cotton Grass: Flowering Conifer or Spore Producer? Unraveling the Mystery
You may want to see also

Effectiveness of Oven Baking
Oven baking is often suggested as a method to kill mold spores on certain items, such as wooden utensils, clay pots, or even fabric. The principle behind this approach is that high temperatures can denature the proteins and enzymes within mold spores, rendering them inactive. However, the effectiveness of this method depends on several factors, including the temperature, duration, and the material being treated. For instance, baking at 140°F (60°C) for 30 minutes is generally recommended for items that can withstand heat without damage. This temperature is sufficient to kill most mold spores without causing harm to heat-resistant materials like glass or metal.
When considering oven baking as a mold remediation technique, it’s crucial to assess the item’s heat tolerance. Delicate fabrics, plastics, or painted surfaces may warp, melt, or discolor under high temperatures, making this method unsuitable. For example, while baking a ceramic dish at 300°F (150°C) for 10–15 minutes can effectively eliminate mold, attempting the same with a plastic container could result in toxic fumes or permanent damage. Always check the manufacturer’s guidelines or test a small area before proceeding. Additionally, ensure proper ventilation during the process to avoid inhaling any residual mold particles or fumes.
A comparative analysis reveals that oven baking is more effective for non-porous materials than porous ones. Mold spores can penetrate deep into porous surfaces like wood or fabric, making it difficult for surface-level heat to reach and destroy them. In such cases, baking may only address visible mold while leaving hidden spores intact. For porous items, combining baking with other methods, such as vinegar or hydrogen peroxide treatment, can improve results. For instance, pre-soaking a wooden spoon in a vinegar solution before baking can enhance mold removal by loosening spores before heat application.
To maximize the effectiveness of oven baking, follow these practical steps: first, clean the item to remove visible mold using a brush or cloth. Next, place the item on a baking sheet lined with foil or parchment paper to catch any debris. Set the oven to the recommended temperature (e.g., 140°F for heat-sensitive items or 300°F for durable materials) and bake for the specified duration. After baking, allow the item to cool completely before handling. For added safety, wear gloves and a mask during the cleaning and baking process to avoid exposure to mold spores.
Despite its utility, oven baking is not a one-size-fits-all solution. It is most effective for small, heat-resistant items and should be avoided for large or delicate objects. For extensive mold infestations, professional remediation may be necessary. While baking can kill mold spores on the surface, it does not address the underlying cause of mold growth, such as moisture or humidity. Pairing this method with preventive measures, like improving ventilation or using dehumidifiers, ensures long-term success in mold control. In summary, oven baking is a viable, cost-effective option for targeted mold removal when applied thoughtfully and in appropriate contexts.
Are Spore Prints Illegal? Understanding Legal Boundaries in Mycology
You may want to see also

Impact on Food Safety
Baking is often seen as a reliable method to eliminate harmful pathogens in food, but its effectiveness against mold spores is a nuanced issue. Mold spores are resilient and can survive temperatures that would kill most bacteria. While baking at temperatures above 140°F (60°C) can deactivate many mold spores, it is not a guaranteed method for complete eradication. This is because some mold species produce heat-resistant structures called spores that can withstand typical baking temperatures. For instance, *Aspergillus* and *Penicillium* species are known to survive temperatures up to 250°F (121°C) for extended periods. Therefore, relying solely on baking to ensure food safety in the presence of mold is risky.
To minimize food safety risks, it’s crucial to inspect ingredients before baking. Visible mold on bread, fruits, or vegetables is a clear sign of contamination, and baking will not render these items safe. Moldy foods should be discarded immediately, as toxins like aflatoxins and ochratoxins produced by mold can persist even after baking. These toxins are heat-stable and can cause severe health issues, including liver damage and immune system suppression. For example, baking moldy bread will not eliminate aflatoxins, which are carcinogenic even in small amounts. Always follow the rule: "When in doubt, throw it out."
When baking with ingredients that are prone to mold, such as nuts, grains, or dried fruits, proper storage is key. Store these items in airtight containers in a cool, dry place to prevent mold growth. If you suspect mold but cannot see it, use your senses—a musty smell or unusual texture can indicate hidden spores. For baked goods, ensure thorough cooking by using a food thermometer to confirm internal temperatures reach at least 160°F (71°C), which can help reduce, but not eliminate, mold risks. However, this temperature is primarily effective against bacteria, not mold spores.
For those with weakened immune systems, such as the elderly, pregnant individuals, or people with HIV/AIDS, the risks of consuming mold-contaminated food are significantly higher. Even trace amounts of mold toxins can lead to severe health complications. In such cases, preventive measures are paramount. Avoid using ingredients past their expiration dates, and inspect baked goods for any signs of mold before consumption. Additionally, consider using natural mold inhibitors like vinegar or lemon juice in recipes, though these are not foolproof against spores.
In conclusion, while baking can reduce the presence of mold spores, it is not a reliable method for ensuring food safety in mold-contaminated items. The heat resistance of mold spores and the persistence of toxins mean that prevention is the best strategy. Proper storage, thorough inspection, and immediate disposal of moldy foods are essential practices to protect against foodborne illnesses. When it comes to mold, baking is not a cure-all—it’s better to be safe than sorry.
Exploring Legal Ways to Obtain Psychedelic Mushroom Spores Safely
You may want to see also
Explore related products
$13.48 $14.13

Mold Survival in Bread
Mold spores are remarkably resilient, and bread provides an ideal environment for their growth due to its moisture and nutrient content. When mold appears on bread, it’s tempting to think that baking might eliminate the problem. However, while baking temperatures (typically 350°F/175°C and above) can kill surface mold, they often fail to penetrate deeply enough to destroy spores embedded within the bread’s structure. These spores can survive temperatures up to 250°F/121°C for extended periods, making them difficult to eradicate through conventional baking methods. This survival mechanism allows mold to regrow once conditions become favorable again, such as when the bread cools and moisture returns.
To effectively address mold in bread, it’s crucial to understand the limitations of baking as a solution. For instance, if mold is visible on the surface, cutting off the affected area and baking the remaining bread at 350°F for 10–15 minutes can reduce surface contamination. However, this method is not foolproof, as spores may already have spread internally. A more reliable approach is to discard moldy bread entirely, especially for individuals with mold allergies or weakened immune systems. Mold produces mycotoxins, which can persist even after baking and pose serious health risks if ingested.
Comparing baking to other methods reveals its inefficiency in mold eradication. Freezing, for example, can halt mold growth but does not kill spores. Microwave treatment, while more effective than baking, may unevenly heat the bread, leaving pockets of surviving spores. The most effective solution is prevention: store bread in a cool, dry place, and use airtight containers to minimize moisture exposure. For homemade bread, ensure it cools completely before storing to prevent condensation, which fosters mold growth.
Practically, if you suspect mold but see no visible signs, trust your senses. Mold can grow internally, producing a musty odor or off-flavor before becoming visible. In such cases, discard the bread immediately. For those determined to salvage partially affected bread, consider using it for croutons or bread pudding after removing all visible mold and baking thoroughly. However, this carries a risk and is not recommended for consumption by vulnerable populations. Ultimately, the safest approach is to prioritize prevention and disposal over attempted remediation.
Do Free Spores Stain Green? Unveiling the Truth Behind the Myth
You may want to see also

Alternative Mold Removal Methods
Baking, specifically using high temperatures, can reduce mold spore viability, but it’s not a foolproof method for complete eradication. Mold spores are resilient and can survive temperatures that kill active mold colonies. For those seeking alternative mold removal methods, natural remedies and household items offer viable options, though their effectiveness varies based on application and mold severity.
Vinegar and Hydrogen Peroxide: A Dynamic Duo
White vinegar, a mild acid, disrupts mold’s pH balance, while 3% hydrogen peroxide acts as an oxidizing agent to break down mold cells. To use, spray undiluted white vinegar on the affected area, let it sit for an hour, then scrub. Follow by spraying hydrogen peroxide, allowing it to sit for 10 minutes, and wiping clean. This method is safe for non-porous surfaces like tiles and glass but may discolor fabrics or wood. Avoid mixing vinegar and hydrogen peroxide directly, as it creates peracetic acid, a harsh irritant.
Tea Tree Oil: Nature’s Antimicrobial
Tea tree oil’s antifungal properties make it a potent mold inhibitor. Mix 1 teaspoon of tea tree oil with 1 cup of water in a spray bottle. Apply to moldy areas, leave for 3–4 hours, then wipe away. Its strong scent lingers, acting as a natural repellent. However, tea tree oil is expensive and best suited for small infestations. Dilution is key, as concentrated oil can damage surfaces or irritate skin.
Baking Soda: Beyond the Oven
Baking soda absorbs moisture and neutralizes mold odors. Create a paste with water (1:1 ratio) and apply to moldy spots. Let it dry, then scrub off. For prevention, sprinkle dry baking soda in damp areas like basements. While it doesn’t kill spores directly, it disrupts their growth environment. Pairing it with vinegar enhances cleaning power but requires immediate application to avoid fizzing.
Steam Cleaning: Heat Without the Oven
Steam cleaners use temperatures above 140°F (60°C) to kill mold on contact, ideal for porous materials like grout or upholstery. Ensure the surface can withstand heat and moisture. Follow up by wiping away residue to prevent spore resettlement. This method is eco-friendly but requires equipment and caution to avoid burns.
Each alternative method has its niche, from vinegar’s versatility to tea tree oil’s potency. While none guarantee 100% spore elimination, consistent application and prevention strategies can manage mold effectively without harsh chemicals. Always test on small areas first and address underlying moisture issues to prevent recurrence.
Can C. Diff Tests Detect Spores? Unraveling Diagnostic Accuracy
You may want to see also
Frequently asked questions
Yes, baking at temperatures above 140°F (60°C) can effectively kill mold spores, as heat denatures their proteins and disrupts their cell structure.
A temperature of at least 300°F (150°C) for 10–15 minutes is generally sufficient to kill mold spores on food items or surfaces.
Baking can kill mold spores on some foods, but it’s not recommended for porous items like bread or soft fruits, as mold toxins (mycotoxins) may remain even after baking.
No, baking does not eliminate mycotoxins, which are heat-stable and can remain in food even after mold spores are killed. It’s best to discard heavily moldy items.

























